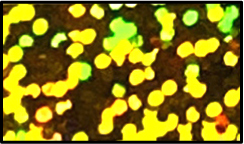

Color Sample
色見本
ご覧のモニターにより、多少色味が異なる場合がございます。
加工方法によって対応できないカラーもございます。
シルクプリント 色見本
※印の7色は特殊なインクの為プリント代が異なります。
カッティングシートプリント 色見本
STANDARD RMS 【艶消スタンダード】
-

RMS-11
エンジ
-

RMS-12
レッド
-

RMS-13
ファイヤーレッド
-

RMS-14
オレンジ
-

RMS-15
キャロット
-

RMS-16
イエロー
-

RMS-17
レモン
-

RMS-20
フレッシュグリーン
-

RMS-22
グリーン
-

RMS-23
ダークグリーン
-

RMS-28
ブルーグリーン
-

RMS-29
カーキ
-

RMS-30
パステルブルー
-

RMS-31
クールブルー
-

RMS-32
スカイブルー
-

RMS-33
ブルー
-

RMS-35
ネイビー
-

RMS-41
パープル
-

RMS-42
チェリーピンク
-

RMS-43
パステルピンク
-

RMS-44
ピンク
-

RMS-45
ラベンダー
-

RMS-47
キャメル
-

RMS-48
ブラウン
-

RMS-52
ホワイト
-

RMS-56
グレー
-

RMS-59
ブラック
-

RMS-N14
ネオンオレンジ
-

RMS-N16
ネオンイエロー
-

RMS-N22
ネオングリーン
-

RMS-N33
ネオンブルー
-

RMS-N44
ネオンピンク
-

RMS-19
ゴールド
-

RMS-54
シルバー
MULTI RMM 【艶消マルチ/撥水・ナイロン用、昇華防止】
-

RMM-111
エンジ
-

RMM-121
レッド
-

RMM-131
ファイヤーレッド
-

RMM-141
オレンジ
-

RMM-140
パステルオレンジ
-

RMM-151
マスタード
-

RMM-161
イエロー
-

RMM-162
レモン
-

RMM-160
パステルイエロー
-

RMM-220
パステルグリーン
-

RMM-222
フレッシュグリーン
-

RMM-223
ライム
-

RMM-221
グリーン
-

RMM-224
ターコイズ
-

RMM-332
スカイブルー
-

RMM-334
パステルブルー
-

RMM-331
ブルー
-

RMM-335
ロイヤルブルー
-

RMM-333
ネイビー
-

RMM-401
バイオレット
-

RMM-411
パープル
-

RMM-412
ダークパープル
-

RMM-441
ピンク
-

RMM-442
マゼンタ
-

RMM-443
チェリーピンク
-

RMM-481
ブラウン
-

RMM-521
ホワイト
-

RMM-561
ライトグレー
-

RMM-551
グレー
-

RMM-591
ブラック
-

RMM-N121
ネオンレッド
-

RMM-N141
ネオンオレンジ
-

RMM-N161
ネオンイエロー
-

RMM-N221
ネオングリーン
-

RMM-N441
ネオンピンク
-

RMM-P331
ブルーオパール
-

RMM-P330
サファイア
-

RMM-P521
パールホワイト
-

RMM-191
ゴールド
-

RMM-541
シルバー
-

RMM-471
カッパー
PRIME RMG 【艶消プライム】
BOND STANDARD RWG【撥水・ナイロン生地用】
-

RMG / RWG-12
レッド
-

RMG-13
ファイヤーレッド
-

RMG / RWG-14
オレンジ
-

RMG / RWG-16
イエロー
-

RMG-17
レモン
-

RMG-20
フレッシュグリーン
-

RMG / RWG-22
グリーン
-

RMG-30
パステルブルー
-

RMG / RWG-32
スカイブルー
-

RMG / RWG-33
ブルー
-

RMG / RWG-35
ネイビー
-

RMG-42
チェリーピンク
-

RMG-44
ピンク
-

RMG-47
ベージュ
-

RMG / RWG-52
ホワイト
-

RMG / RWG-56
グレー
-

RMG / RWG-59
ブラック
-

RMG-18
オールドゴールド
-

RMG / RWG-N42
ネオンマゼンタ
-

RMG / RWG-19
ゴールド
-

RMG / RWG-54
シルバー
QUICK MAT RQM【艶消クイックマット】
-

RQM-12
レッド
-

RQM-14
オレンジ
-

RQM-16
イエロー
-

RQM-17
レモン
-

RQM-20
フレッシュグリーン
-

RQM-21
ライム
-

RQM-22
グリーン
-

RQM-32
スカイブルー
-

RQM-33
ブルー
-

RQM-35
ネイビー
-

RQM-40
バイオレット
-

RQM-44
ピンク
-

RQM-56
グレー
-

RQM-52
ホワイト
-

RQM-59
ブラック
-

RQM-N14
ネオンオレンジ
-

RQM-N16
ネオンイエロー
-

RQM-N22
ネオングリーン
-

RQM-N44
ネオンピンク
-

RQM-19
ゴールド
-

RQM-54
シルバー
SUPER STRETCHING RSS 【艶消スーパーストレッチ】
-

RSS-52
ホワイト
-

RSS-59
ブラック
-

RSS-19
ゴールド
-

RSS-54
シルバー
GROSS STANDARD RGS 【艶有スタンダード】
-

RGS-12
レッド
-

RGS-17
レモン
-

RGS-33
ブルー
-

RGS-50
ホワイト
-

RGS-58
ブラック
-

RGS-18
ゴールドラメ
-

RGS-53
シルバーラメ
SUBLI BLOCK RBO 【昇華防止】
-

RBO-12
レッド
-

RBO-14
オレンジ
-

RBO-16
イエロー
-

RBO-22
グリーン
-

RBO-33
ブルー
-

RBO-52
ホワイト
-

RBO-19
ゴールド
-

RBO-54
シルバー
PEARL GLITTER TSG 【パールグリッター】
-

RSG-12
レッド
-

RSG-14
オレンジ
-

RSG-16
イエロー
-

RSG-20
フレッシュグリーン
-

RSG-22
グリーン
-

RSG-27
エメラルド
-

RSG-28
ミント
-

RSG-29
カーキ
-

RSG-33
ブルー
-

RSG-34
サファイア
-

RSG-35
ネイビー
-

RSG-38
ロイヤルブルー
-

RSG-40
バイオレット
-

RSG-41
パープル
-

RSG-42
チェリーピンク
-

RSG-43
ローズピンク
-

RSG-44
ピンク
-

RSG-49
ブラウン
-

RSG-50
ホワイト
-

RSG-57
クローム
-

RSG-58
ブラック
-

RSG-19
ゴールド
-

RSG-54
シルバー
-

RSG-77
マルチカラー
-

RSG-H52
ホロホワイト
-

RSG-H44
ホロピンク
-

RSG-H19
ホロゴールド
-

RSG-H54
ホロシルバー
-

RSG-N14
ネオンオレンジ
-

RSG-N16
ネオンイエロー
-

RSG-N30
ネオンブルー
-

RSG-N44
ネオンピンク
TWINKLE RTG 【トゥインクル】
-

RTG-12
レッド
-

RTG-14
オレンジ
-

RTG-22
グリーン
-

RTG-33
ブルー
-

RTG-44
ピンク
-

RTG-58
ブラック
-

RTG-19
ゴールド
-

RTG-54
シルバー
GLITTER RSP 【グリッター】
-

RSP-00
クリア
-

RSP-41
パープル
-

RSP-50
ホワイト
-

RSP-58
ブラック
-

RSP-19
ゴールド
-

RSP-54
シルバー
REFLECT RSR 【反射】
-

RSR-50
ホワイト
-

RSR-58
ブラック
-

RSR-19
ゴールド
-

RSR-54
シルバー
-

RSR-N14
ネオンオレンジ
-

RSR-N16
ネオンイエロー
-

RSR-N22
ネオングリーン
-

RSR-N44
ネオンピンク
HOLOGRAM MINIDOT RHM 【ホログラムミニドット】
-

RHM-12
レッド
-

RHM-31
アイスブルー
-

RHM-42
チェリーピンク
-
RHM-19
ゴールド
-

RHM-54
シルバー
-

RHM-S77
レインボーストライプ
-

RHM-D77
レインボードット
HOLOGRAM SPRINTER RHS 【ホログラムスプリンター】
-

RHS-19
ゴールド
-

RHS-54
シルバー
HOLOGRAM PLAIN RHP 【ホログラムプレーン】
-

RHP-54
シルバー
-

RHP-77
アイリス
LUMINOUS RTU 【蓄光】
-

RTU-01
蓄光
PRINT PATTERN RPK 【プリントパターン】
-

RPK-001
ヒョウ
-

RPK-002
ゼブラ
-

RPK-002
カモフラピンク
-

RPK-010
カモフラグレー
DELUXE RMA 【デラックス】
-

RMA-52
ホワイト
-

RMA-59
ブラック
BUBBLEUP RAP 【発泡バブルアップ】
-

RAP-52
ホワイト
-

RAP-59
ブラック
FLOCK RFL 【フロッキー】
-

RFL-12
レッド
-

RFL-14
オレンジ
-

RFL-16
イエロー
-

RFL-17
レモン
-

RFL-21
パステルグリーン
-

RFL-22
グリーン
-

RFL-32
スカイブルー
-

RFL-33
ブルー
-

RFL-35
ネイビー
-

RFL-42
チェリーピンク
-

RFL-44
ピンク
-

RFL-48
ブラウン
-

RFL-56
グレー
-

RFL-52
ホワイト
-

RFL-59
ブラック
DOUBLE EDGE RDE 【ダブルエッジ】
-

RDE-5212
ホワイト/レッド
-

RDE-5216
ホワイト/イエロー
-

RDE-5222
ホワイト/グリーン
-

RDE-5233
ホワイト/ブルー
-

RDE-5259
ホワイト/ブラック
-

RDE-5952
ブラック/ホワイト
METALLIC MIRROR RMZ 【メタリックミラー】
-

RMZ-12
レッド
-

RMZ-32
スカイブルー
-

RMZ-42
チェリーピンク
-

RMZ-19
ゴールド
-

RMZ-54
シルバー
-

RMZ-57
クローム
METALLIC FOIL RSZ 【ストレッチミラー】
-

RSZ-12
レッド
-

RSZ-14
オレンジ
-

RSZ-20
イエローグリーン
-

RSZ-22
グリーン
-

RSZ-32
スカイブルー
-

RSZ-33
ブルー
-

RSZ-41
パープル
-

RSZ-42
チェリーピンク
-

RSZ-44
ピンク
-

RSZ-48
ブラウン
-

RSZ-57
クローム
-

RSZ-58
ブラック
-

RSZ-19
ゴールド
-

RSZ-54
シルバー
-

RSZ-M19
マットゴールド
-

RSZ-M54
マットシルバー
CARBON RXB 【カーボン】
-

RXB-52
ホワイト
-

RXB-59
ブラック
-

RXB-59
ゴールド
-

RXB-54
シルバー
LEATHER RXD 【レザー】
-

RXD-003
レザー


















































